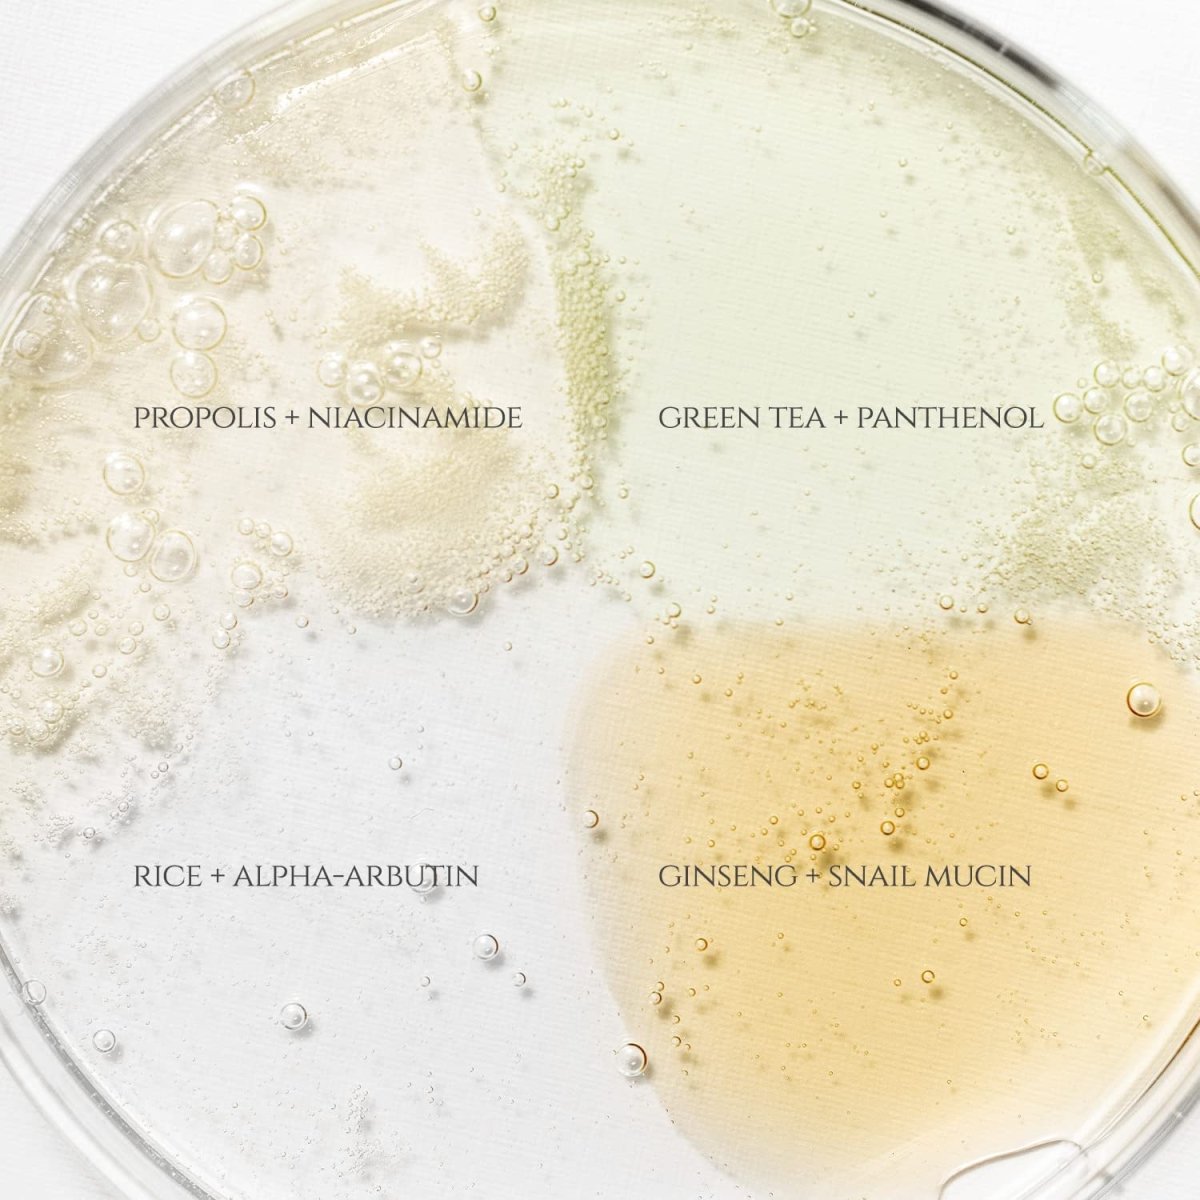

نحن نتعامل بشكل مباشر بنسبة 100% مع العلامات التجارية، كما أننا معتمدون من قبل بلدية دبي
يمكنك أيضًا الاستلام من متجرنا.
مركز مدينة ديرة
السطوة
الوحدة مول أبو ظبي
للحصول على تفاصيل الشحن،
- دبي من يوم إلى يومين
- الإمارات الأخرى 2 - 3 أيام
- مجلس التعاون الخليجي 3-5 أيام
بلد آخر
7-10 أيام